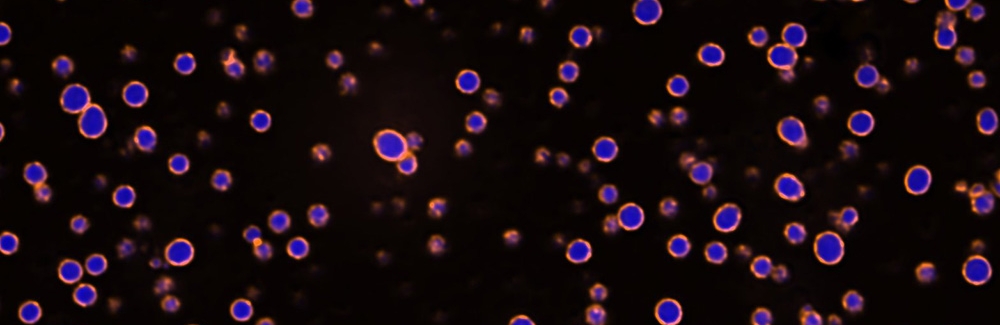
condensates - paraspeckles

Physiology Course Project Leads to Insight on How Condensates Form
A research project that began in the 2021 MBL Physiology course and showed promise, then was pursued for years after by a student/faculty team as their careers advanced, was published last week in Proceedings of the National Academy of Sciences.
Lead author Wilton Snead was a teaching assistant in the Physiology course with faculty member Amy Gladfelter, and co-author Krishna Shrinivas was a student. After the course ended, the three continued to collaborate, with Shrinivas visiting Gladfelter’s lab (then at University of North Carolina-Chapel Hill).
“Since then, Krishna and I both started faculty positions at Northwestern University, and we are now planning many other long-term collaborations between our labs,” Snead says.
Their PNAS paper shows how important condensates called paraspeckles form in the nucleus of cells.
“Paraspeckles are important in many functions in the cell, including immune activation and early development,” Snead says. Like many other condensates, paraspeckles are “droplets” containing protein and RNA molecules that are temporarily held together by forces of attraction.
“We discovered that paraspeckles form through a mechanism that is quite different than previously thought,” Snead says. “Using biochemical reconstitution and computer simulations, we found that paraspeckle proteins all prefer to bind the same parts of the scaffold RNA, leading to a competition that drives the internal organization of proteins into distinct layers.”
In addition to the importance of paraspeckles in normal functioning of the immune, cardiovascular, and central nervous systems, paraspeckles are dysregulated in many kinds of cancer. This foundational work “has the potential to impact the work of scientists around the world and may one day aid in the design of new cancer drugs,” Gladfelter told Northwestern University.
Gladfelter, now at Duke University, and Clifford Brangwynne of Princeton University currently co-direct the MBL Physiology course.
Photo caption (above):
Biomolecular condensates reconstituted in vitro with a short fragment of the RNA NEAT1 and the RNA-binding proteins FUS (blue) and TDP-43 (orange). The proteins spontaneously arrange into core and shell layers when mixed with the RNA, mimicking their native arrangement within condensates called paraspeckles. Credit: Wilton T. Snead, Northwestern University
Citation:
Wilton T. Snead, Mary K. Skillcorn, Krishna Shrinivas and Amy S. Gladfelter (2025) Immiscible proteins compete for RNA binding to order condensate layers. Proc. Natl. Acad. Sci., DOI: 10.1073/pnas.2504778122